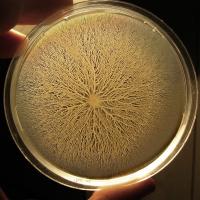

- Curiosità
Articolo
La più famosa rimane l'appendice, ma sono molte di più le parti del corpo che “non servono più”.
A metterne in fila nove in una serie di tweet, poi ripresi da diversi siti statunitensi, è stata Dorsa Amir, una antropologa evoluzionista del Boston College. Questi ed altri “rifiuti dell'evoluzione”, spiega l'esperta, sono chiamati “strutture... Continua
Articolo
L'intelligenza artificiale ha imparato a dormire e forse in futuro imparerà anche a sognare: un po' come i replicanti di Ma gli androidi sognano pecore elettriche? (Do Androids Dream of Electric Sheep?, 1968), romanzo di Philip K. Dick che ha ispirato il famosissimo film Blade Runner (1982) di Ridley Scott.
Un progetto tutto italiano ha realizzato... Continua
Articolo
Non morì per un'infezione, alcolismo (sebbene il suo declino inizio proprio con una forte bevuta) o un omicidio Alessandro Magno, come alcune tesi storiche hanno nel tempo sostenuto. Bensì a causa della sindrome di Guillain-Barré, un disturbo neurologico raro autoimmune che lo lasciò paralizzato per sei giorni, privandolo a poco a poco della... Continua
Articolo
Il cervello delle donne invecchia più lentamente e, a parità di età, è almeno tre anni più giovane rispetto a quello maschile.
Lo indica una ricerca dell'Università Washington a Saint Louis (Missouri) pubblicata sulla rivista dell'Accademia Nazionale delle Scienze degli Stati Uniti, PNAS. Il risultato, basato sulla scansione del cervello di 205... Continua
Articolo
Sono pronti i primi risultati parziali dell'esperimento più lungo della storia, avviato nel 2014 e destinato a durare ben 500 anni, fino al 2514, per scoprire quanto possono sopravvivere i batteri dormienti in isolamento. Sigillati in 800 fiale di vetro come in una capsula del tempo, i batteri verranno analizzati un po' per volta a intervalli... Continua
Articolo
Altezza e peso possono essere alcuni dei segreti di lunga vita per le donne, ma non per gli uomini.
Per entrambi i sessi, però, vale il principio che l'esercizio fisico allunga la vita. È questo il risultato della ricerca pubblicata sul Journal of Epidemiology and Community Health e coordinata dalla Scuola di Oncologia e Biologia dello Sviluppo... Continua
Articolo
Da sempre il mese di gennaio porta con sé il momento di fissare obiettivi e buoni propositi, dal classico “rimettersi in forma e mangiare meglio” alle intenzioni di affrontare la vita quotidiana con maggiore positività o provare a vincere le proprie paure.
Ed è proprio su una delle paure più diffuse che Rentokil, leader mondiale in servizi di... Continua
Articolo
Essere cullati migliora la qualità del sonno, aiuta ad addormentarsi più in fretta e a dormire più profondamente, infine potenzia la memoria (attraverso il consolidamento dei ricordi durante il sonno).
Lo rivelano due studi entrambi condotti in Svizzera e pubblicati sulla rivista Current Biology, uno svolto con animali, l'altro con un gruppo di... Continua
Articolo
Per la prima volta al mondo, in un supermercato di Berlino sono state vendute uova da allevamenti che non uccidono i pulcini maschi, come avviene di norma.
L'innovazione è stata introdotta, come spiega il quotidiano britannico Guardian, da REWE Group, azienda tedesca operante nel settore della grande distribuzione organizzata e del turismo.
Negli... Continua
Articolo
Sopprimere le idee ovvie per “raggiungere” le più innovative. È così che il cervello umano lavora sulla creatività. Lo rivela uno studio della Queen Mary University of London e della Goldsmiths, University of London pubblicato su Proceedings of the National Academy of Sciences.
La ricerca mostra che le onde cerebrali svolgono un ruolo cruciale... Continua